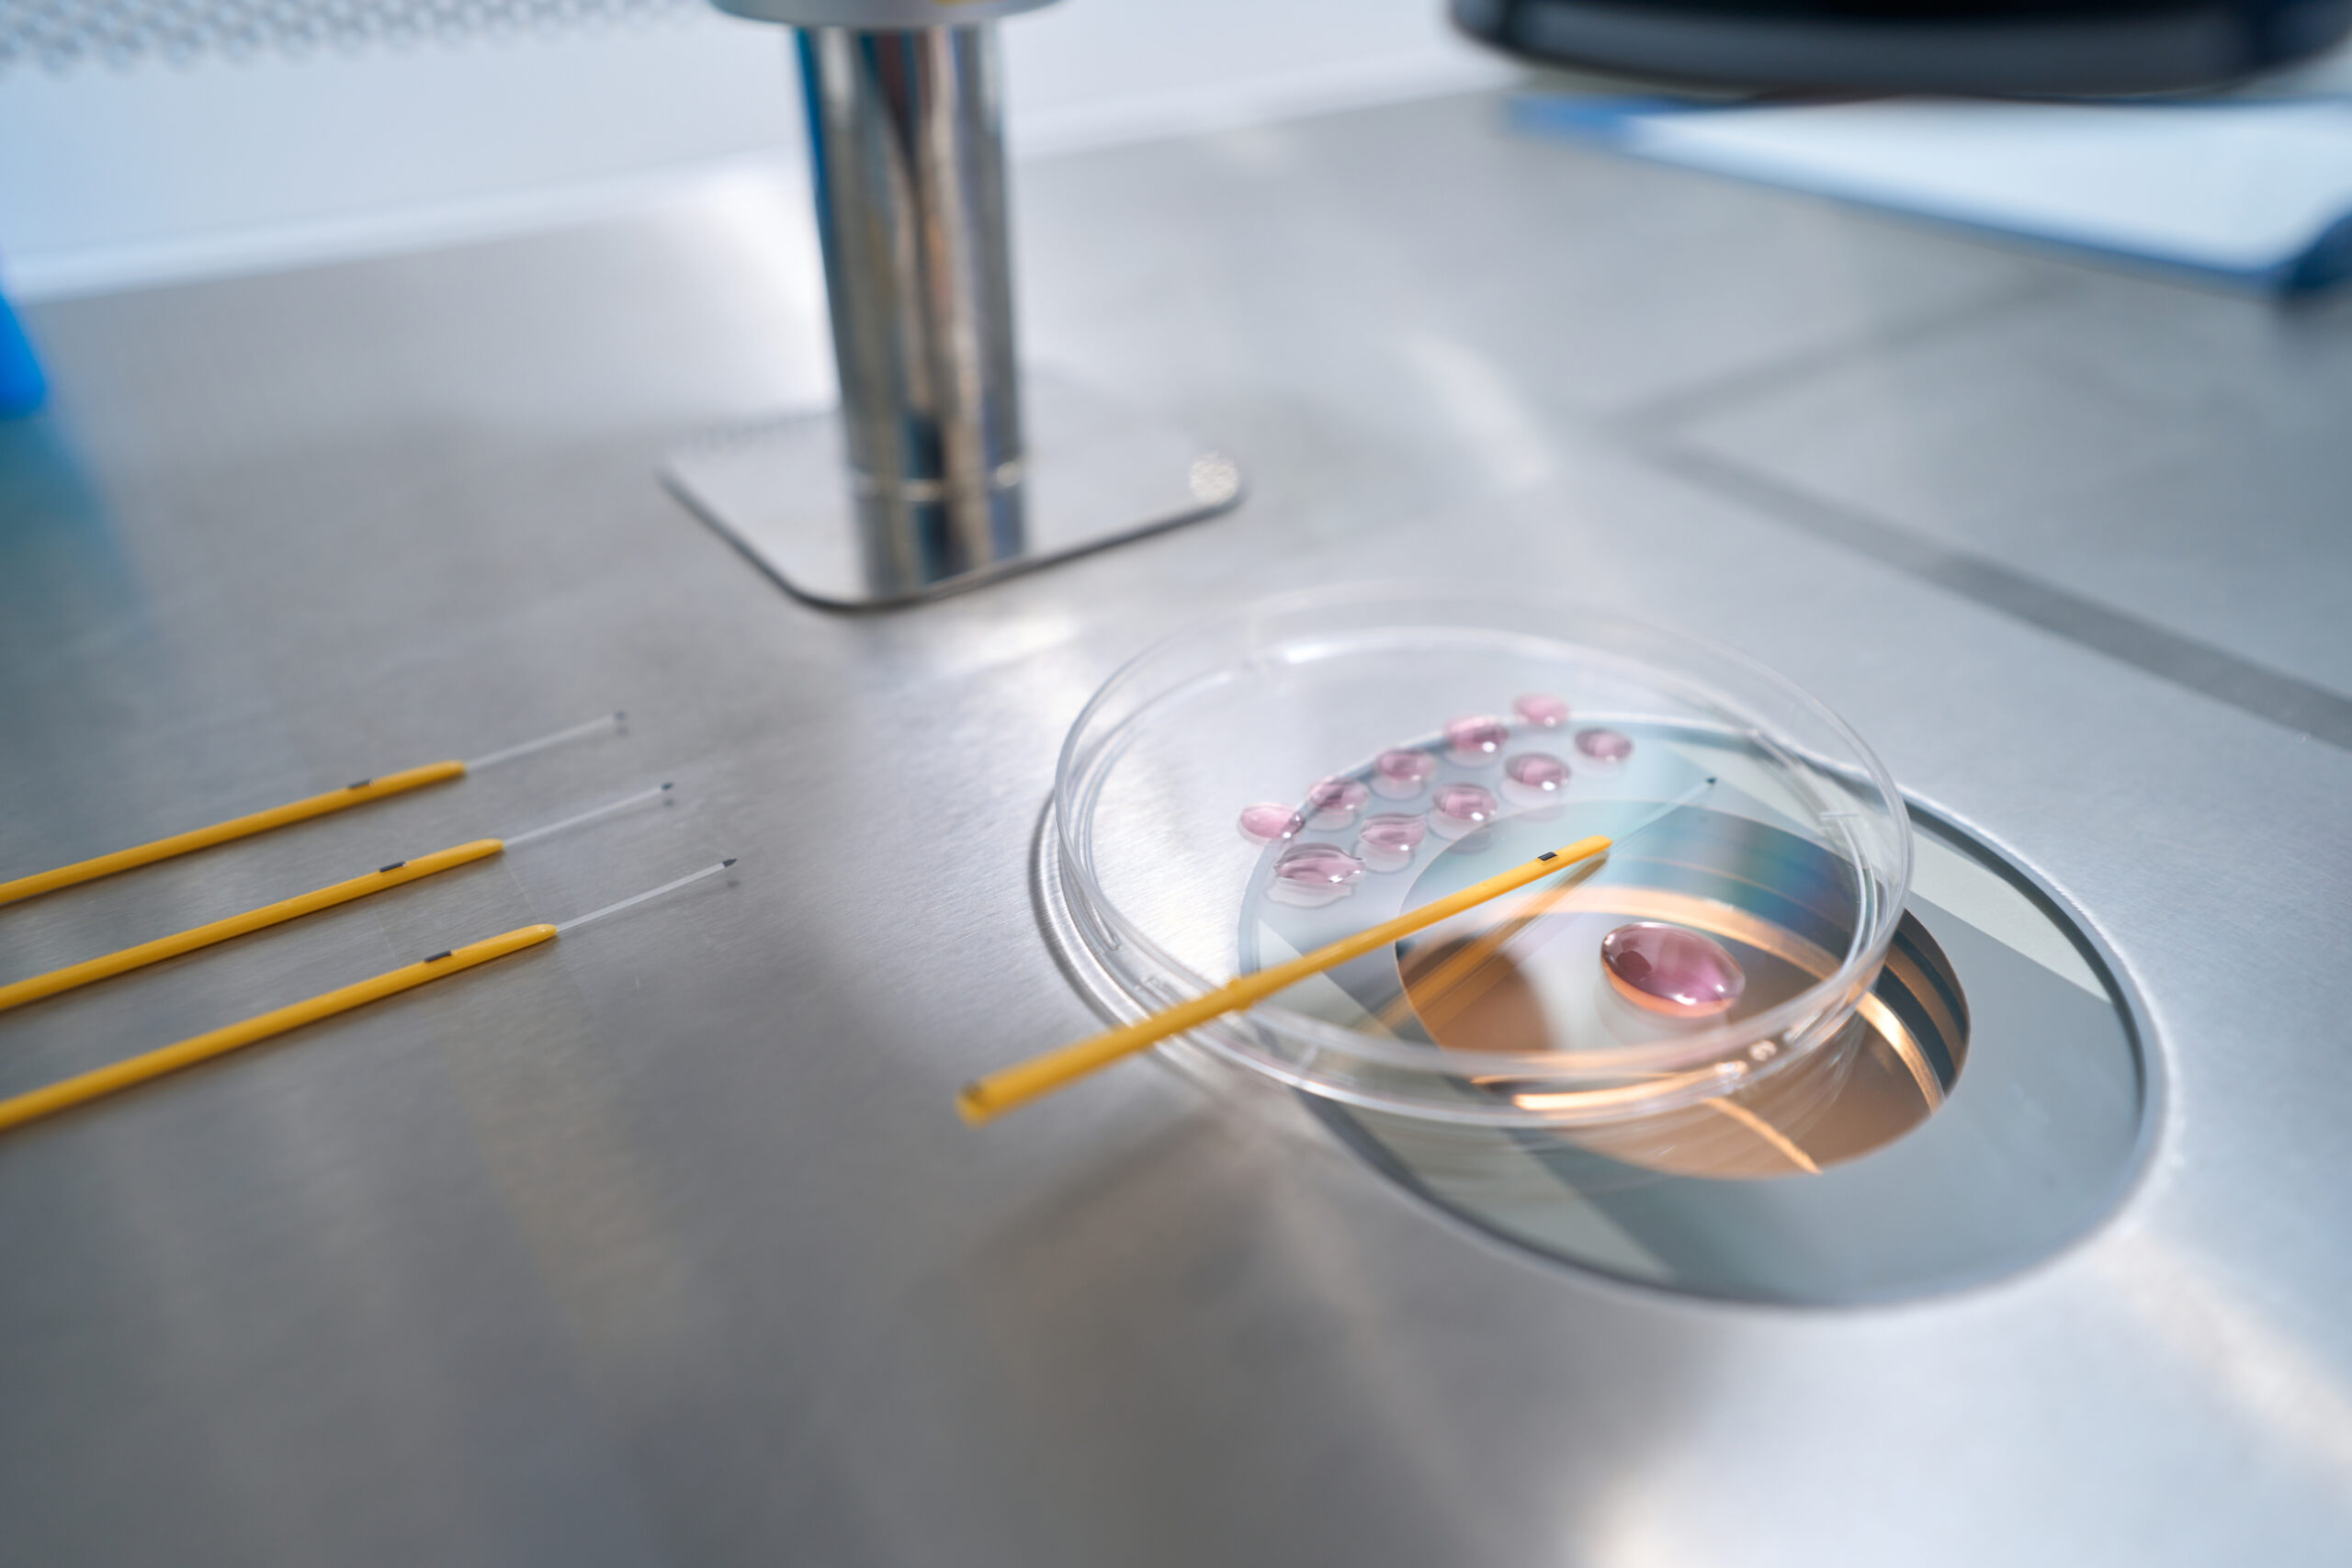

Compassionate care. World-class science. Personalized for you.
Fertility Services & Treatment Options
At OriginElle, we offer a complete range of fertility services — from diagnostic testing to advanced IVF procedures — tailored to your unique path to parenthood. Whether you're just starting or seeking a second opinion, our team is here to support, guide, and empower you every step of the way.
Our Main Services
Fertility Treatments
• IVF (In Vitro Fertilization)
• ICSI (Intracytoplasmic Sperm Injection)
• Egg Donation IVF Cycle
• Frozen Embryo Transfer Cycle (FERC)
• Frozen Egg IVF Cycle (FORC) — includes one transfer and one year of storage
• PGT-A (Chromosome Analysis)
• PGT-M (Genetic Condition Screening)
• PGT-SR (Preimplantation Genetic Testing for Structural Rearrangements)
• IVM (In vitro maturation)
Imaging
• Baseline Ultrasound
• Sonohysterogram (Fallopian Tubes, Uterine Cavity Assessment & HyFoCy)
• Mock Transfer (Uterine Cavity Length Assessment)
• Vitality Scan
• Monitoring Ultrasound
Andrology
• DNA fragmentation
Other Services
• Assisted Hatching (AH)
• Zymot
• Embryo Glue
• Embryoscope (Time Lapse Monitoring)
• TESA
Detailed Services & Care Path
Your Fertility Care Path
At our clinic, we recognize that each individual and couple brings a unique story to their fertility journey. We don’t believe in a one-size-fits-all approach. Instead, we guide you through personalized stages tailored to your specific needs.
Initial Consultation
Your journey starts with a comprehensive consultation where our specialists will attentively listen to your concerns, evaluate previous medical treatments, and thoroughly discuss the findings of any tests you’ve undergone. This session may include a transvaginal ultrasound to assess your ovarian reserve. Often, we can outline a treatment plan on your first visit, though additional tests and follow-ups might be required to finalize the best approach for you.
Diagnostic Assessments
Creating an effective treatment plan involves a detailed fertility assessment for you and your partner. This includes a series of blood tests to check your general health and reproductive hormone levels, along with additional imaging tests to inspect the health of your reproductive system.
- Comprehensive hormone analysis through blood work
- Antral follicle count via ultrasound
- Sonohysterogram (Sono HSG) to examine the uterine cavity and Fallopian tubes
- Sperm concentration, morphology, motility and DNA fragmentation of sperm by WHO criteria
Personalized Treatment Plans
Your treatment will be meticulously planned by your doctor based on your individual needs and medical background. This might include a variety of tests and procedures, supported throughout by your dedicated care team.
Treatment options at our clinic include:
- Management of ovulatory disorders
- Minimally invasive reproductive surgeries
- Methods to induce ovulation
- Intrauterine insemination (IUI) - (RAMQ and OHIP coverage options)
- In vitro fertilization (IVF) - (RAMQ and OHIP coverage options)
- Solutions for third-party and reciprocal reproduction
- Support for those using gender affirming hormones in reproductive contexts
- Intracytoplasmic Sperm Injection (ICSI) (RAMQ and OHIP coverage options)
- PGT-A
- PGT-M
- PGT-SR
Managing Unexplained Infertility
For those facing unexplained infertility—where a clear cause isn’t identified—our clinic remains optimistic and equipped to help you achieve pregnancy. We offer several advanced reproductive techniques, such as:
- Fertility-enhancing medications
- Intrauterine insemination (IUI)
- In vitro fertilization (IVF)
Sperm Health Management
Sperm health significantly impacts fertility, and our clinic is skilled in diagnosing and treating various sperm-related issues. Lifestyle adjustments and assisted reproductive technologies are among the solutions we provide to overcome these challenges.
🌸 Detailed Services & Procedures 🌸
Initial Consultation 🌸
Achieving your dream of parenthood begins with a thorough diagnosis. We recommend a consultation if you are under 35 and have not conceived after one year of regular, unprotected sex, or if you are over 35 and have not conceived after six months. This is also crucial if you face challenges in sustaining pregnancies. We extend our services to everyone, including LGBTQ+ individuals, ensuring that all community members receive personalized and respectful care.

In Vitro Fertilization (IVF) 🌸
IVF mimics natural fertilization by combining eggs and sperm in a controlled laboratory environment. This process aims to create viable embryos that are then transferred to the uterus, initiating pregnancy.

Intracytoplasmic Sperm Injection (ICSI) 🌸
ICSI is a specialized form of IVF where a single sperm is injected directly into an egg. This technique is particularly beneficial for overcoming male factor infertility by ensuring that only the most viable sperm is used for fertilization.
Intrauterine Insemination (IUI) 🌸
IUI is a straightforward procedure where prepared sperm is inserted directly into the uterus. This can involve sperm from a partner or a donor, and by reducing the distance the sperm must travel to meet the egg, it enhances the chances of fertilization by creating a more optimal environment.

Sperm and Egg Freezing 🌸
Preserve your fertility for future use through our cryopreservation services by vitrification, ideal for those facing medical treatments, personal choices, or other circumstances that might affect reproductive health.

Genetic Screening and Diagnosis 🌸
Our genetic testing services are designed to identify potential chromosomal and genetic conditions. This is essential for couples who are at risk of passing on genetic disorders to their offspring.

Preimplantation Genetic Testing for Aneuploidies (PGT-A) 🌸
This test checks embryos for sporadic chromosomal abnormalities, helping select the most viable embryo for transfer and increasing the likelihood of a successful pregnancy.

Preimplantation Genetic Diagnosis (PGT-M) 🌸
PGT-M is aimed at reducing the risk of inheriting specific genetic diseases, ensuring healthier outcomes for your future family.

Preimplantation Genetic Testing for Structural Rearrangements (PGT-SR) 🌸
PGT-SR is a specialized genetic test used during IVF to screen embryos for chromosomal structural rearrangements, such as translocations or inversions. These abnormalities can lead to implantation failure, miscarriage, or genetic disorders. By selecting embryos with balanced chromosomes, PGT-SR increases the chances of a healthy pregnancy and successful outcome.
Male Fertility 🌸
- Medications like clomiphene citrate and gonadotropin to correct hormonal imbalances
- Surgical options for structural issues, such as varicocele repair or vasectomy reversal
- Extensive Fertility Testing

Fertility Assessments 🌸
- Comprehensive physical examinations and review of medical histories
- Sonohysterogram (Sono HSG) to evaluate the female reproductive tract
- Comprehensive semen analysis to assess sperm health and viability

Your Dream, Our Help
We guide you, care for you, and make sure you feel supported and empowered —
Every step of your fertility journey.